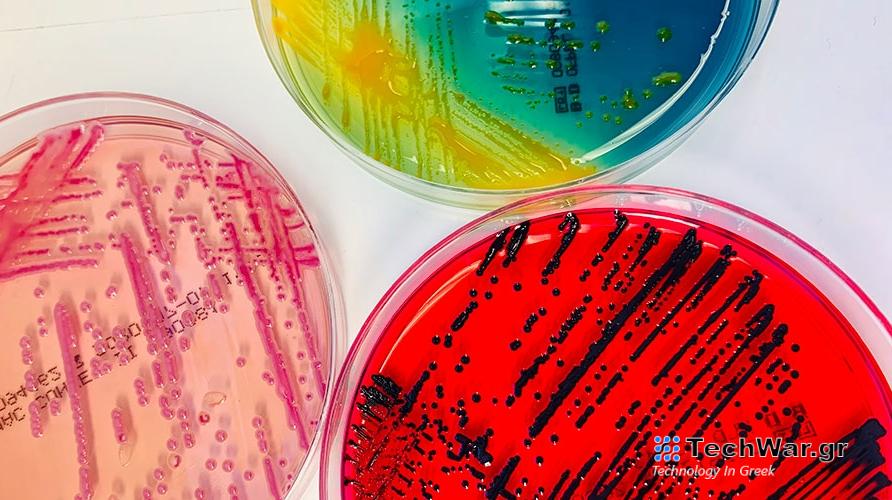
Δεκάδες άγνωστα βακτήρια ανακαλύφθηκαν σε ασθενείς νοσοκομείου

Δεκάδες άγνωστα βακτήρια ανακαλύφθηκαν σε ασθενείς νοσοκομείου
Παρά την πρόοδο της μικροβιολογίας, πολλά βακτήριο είναι δύσκολο ή αδύνατο να καλλιεργηθούν και να μελετηθούν στο εργαστήριο, ή ακόμα και να αναγνωριστούν από ίχνη του γενετικού υλικού τους.
Χάρη όμως σε πρόσφατες εξελίξεις στην
τεχνολογία
του DNA, η
επιστήμη
ανακαλύπτει όλο και περισσότερα μικρόβια που ζούσαν απαρατήρητα ως τώρα πάνω και μέσα στο ανθρώπινο
δέρμα
, ορισμένα από τα οποία φαίνεται πως προκαλούν ασθένειες.
Ερευνητές στην Ελβετία αναφέρουν στην επιθεώρηση
BMC Microbiology
την ανακάλυψη 35 νέων ειδών βακτηρίων σε ασθενείς που νοσηλεύονταν με μια μεγάλη ποικιλία παθήσεων.
Οι νεότερες τεχνικές «θα διευκολύνουν στο μέλλον την ορθή διάγνωση και αντιμετώπιση λοιμώξεων που προκαλούνται από σπάνια παθογόνα» δήλωσε σε
δελτίο Τύπου
ο δρ Ντάνιελ Γκόλντεμπεργκερ του Πανεπιστημίου της Βασιλείας, επικεφαλής της μελέτης.
Για την ταυτοποίηση παθογόνων μικροβίων χρειάζεται συνήθως η καλλιέργειά τους στο εργαστήριο (EPA
Η ομάδα του εξέτασε δείγματα αίματος και ιστών από 61 ασθενείς που νοσηλεύτηκαν από το 2014 και μετά για μια ποικιλία παθήσεων. Οι προσπάθειες καλλιέργειας μικροοργανισμών απέτυχαν όπως και άλλες εργαστηριακές τεχνικές όπως η φασματοσκοπία μάζας και η αλληλούχηση μικρών τμημάτων βακτηριακού DNA.
Χρησιμοποιώντας μια μέθοδο που είναι διαθέσιμη μόνο τα τελευταία χρόνια, οι ερευνητές μπόρεσαν να αλληλουχήσουν το σύνολο του γενετικού υλικού στα δείγματα και να το συγκρίνουν με τις αλληλουχίες γνωστών βακτηρίων σε βάσεις δεδομένων.
Η μελέτη αποκάλυψε 35 άγνωστα ως τώρα
βακτήρια
και 26 που θα ήταν δύσκολο να αναγνωριστούν σε ένα συνηθισμένο εργαστήριο επειδή προστέθηκαν πρόσφατα σε βάσεις δεδομένων ή δεν είχαν ακόμα ονομαστεί.
Από την αξιολόγηση των κλινικών δεδομένων των ασθενών προέκυψε στη συνέχεια ότι 7 από τα 35 νέα είδη πιθανότατα μπορούν να προκαλέσουν λοιμώξεις στον άνθρωπο.
«Τέτοιες άμεσες συνδέσεις ανάμεσα σε νέα είδη βακτηρίων και την κλινική τους σημασία σπάνια δημοσιεύονταν στο παρελθόν» επισήμανε ο Γκόλντενμπεργκερ.
Τα περισσότερα από τα νέα μικρόβια κατατάχθηκαν από τους ερευνητές στα γένη Corynebacterium και Schaalia των θετικών κατά Γκραμ βακτηρίων.
«Πολλά είδη σε αυτά τα δύο γένη απαντούν στο φυσικό μικροβίωμα του ανθρώπινου εντέρου και τους βλεννογόνους. Γι΄αυτό και συχνά υποτιμούνται και οι σχετικές έρευνες είναι λιγοστές» είπε ο επικεφαλής της μελέτης.
Η προσπάθεια της ομάδας του θα συνεχιστεί και πιθανότατα θα αποδώσει πολλές ακόμα ανακαλύψεις.
VIA:
in.gr